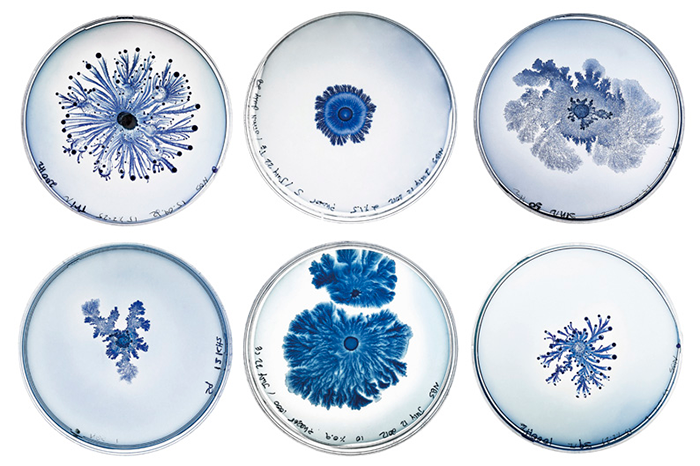

현미경 속 아주 작은 세계
첨부파일
- [지도안] 표현_단원7_활동3_현미경 속 아주 작은 세계.hwp 835.5 KB
미술실이나 학교 주변을 둘러보면서 자신이 찾은 대상을 전자 현미경에 올려 다양한 배율로 사진을 찍어 보자. 사진 속의 이미지에서 새로운 조형 요소를 발견하여 추상화를 그려 보자.

이영진(학생 작품) 환희(종이에 펜, 마커/20×25cm/2010년)

박세영(학생 작품) 원점(종이에 펜, 마커/20×25cm/2010년)

강진(학생 작품) 무제(종이에 포스터 물감/20×25cm/2012년)

이지연(학생 작품)

이현지(학생 작품)

유지연(학생 작품)

권민송(학생 작품)
바르–샤이(Bar-Shai, Nurit/이스라엘) 객관성–음악적 파노라마들(박테리아를 촬영한 디지털 사진/2012년)
세상에 존재하는 생물 중 90%는 우리 인간의 눈에 보이지 않는다. 우리는 겨우 10%의 세계만 보면서 그것이 생물의 전부라고 믿는 셈이다. 이 생각을 바꾸기 위해 예술가와 생물학자가 눈에 보이지 않는 복합적인 세계를 관찰하여 영감을 얻고, 그것을 바탕으로 그림 또는 조각 등으로 재구성했다. 현미경으로 보이는 낯선 생김새를 옮겨 그리다가 우리의 상상력이 더해져 생각하지 못한 결과물을 만들어 내고, 그 과정에서 항상 보던 대로의 방식에서 벗어나 새로운 탐구 방식을 모색할 수 있다.
1. 추상화 작품을 만들 때 어떤 요소가 중요한 역할을 할까? 색상, 형태, 배경은 어떻게 조화를 이룰 수 있을까?
2. 전자 현미경을 통해 본 미시 세계에서 새롭게 발견한 형태와 색은 어떤 의미를 가질 수 있을까?
작성자
미진사 편집부
참고 자료
2015 개정 교육과정 고등학교 미술 교과서 36쪽
2015 개정 교육과정 고등학교 미술 지도서 94쪽
추상 미술 탐구
이동 시점 풍경화 그리기
재료를 이용해 나만의 영웅 만들기
석고로 복제하기
내 삶에서 균형 찾기
좋아하는 조형 요소 찾기
나의 삶을 담은 정물
프레임 속 풍경
원 운동을 이용한 추상화 그리기
현미경 속 아주 작은 세계

댓글0